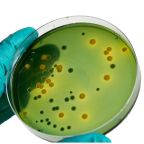
Depositphotos_184476590_XL

Editorial
Entrevista realizada el 26 de noviembre de 2025 por Jerson Andrés Cuéllar Sáenz al Dr. Pedro Villegas Narváez.
Cerramos este año con un profundo sentimiento de gratitud y satisfacción por los logros alcanzados en la comunidad avícola. En nombre de AMEVEA, expresamos un sincero agradecimiento a nuestros asociados, patrocinadores, miembros de la Junta Directiva y de los diferentes comités, cuyo compromiso y apoyo constante han sido clave para la consolidación del 2025 como un año de crecimiento, cooperación y fortalecimiento institucional.
Entrevista realizada en julio de 2025 por el coordinador editorial de la Revista Plumazos Jerson Cuéllar Sáenz al Dr. Santiago Pardo.
Con gran entusiasmo, celebramos la realización del Primer Congreso de Incubación en Santa Marta, un evento que marca un hito para el sector avícola nacional e internacional. Esta edición de Plumazos rinde homenaje a la historia, al presente y al futuro de nuestra industria, destacando los esfuerzos de quienes han sido pilares en su desarrollo.
Con gran entusiasmo, celebramos la realización del Primer Congreso de Incubación en Santa Marta, un evento que marca un hito para el sector avícola nacional e internacional. Esta edición de Plumazos rinde homenaje a la historia, al presente y al futuro de nuestra industria, destacando los esfuerzos de quienes han sido pilares en su desarrollo.
Dr. Santos, han pasado más de 80 ediciones desde que ‘Plumazos’ comenzó a circular en los años 80 desde AMEVEA. ¿Cómo recuerda esos primeros años de la revista? ¿Qué desafíos enfrentaron al crear un medio especializado en avicultura
en ese momento?
Plumazos: Una publicación de la Asociación Colombiana de Médicos Veterinarios y Zootecnistas Especialistas en Avicultura – Amevea
Artículos Cientifícos
La Resistencia Antimicrobiana (RAM) representa uno de los mayores desafíos en la salud pública global, comprometiendo la eficacia de los tratamientos antibióticos y generando un impacto significativo en la medicina humana y veterinaria. Este fenómeno, mediado por elementos genéticos móviles como plásmidos, transposones e integrones, facilita la diseminación de genes de resistencia entre bacterias mediante transferencia horizontal, sin necesidad de replicación bacteriana y contribuye significativamente al fracaso terapéutico en infecciones (Fišarová et al., 2019).
La avicultura constituye uno de los sectores pecuarios de mayor dinamismo y relevancia en la seguridad alimentaria mundial, aportando más del 40 % de la proteína animal consumida globalmente (FAO, 2022). En Colombia, este sector representa un componente estratégico del PIB agropecuario: la Federación Nacional de Avicultores (FENAVI, 2024) reporta una producción anual de 1,8 millones de toneladas de carne de pollo y cerca de 18 mil millones de huevos, con un consumo per cápita estimado de 345 unidades por habitante.
La industria mundial de producción de huevos se enfrenta a una creciente presión para equilibrar la productividad con el bienestar animal. Los métodos de cría intensiva han mejorado significativamente la productividad; sin embargo, los consumidores y los organismos reguladores exigen ahora estándares de bienestar animal más elevados en los sistemas de producción (Lozano-Villegas et al., 2025).
Mycoplasma spp. es una bacteria de la clase Mollicutes, que se caracteriza por no tener pared celular, poseer un genoma pequeño que codifica entre 500 y 1000 genes y un mínimo de organelas para sobrevivir, incluyendo una membrana plasmática, ribosomas y un genoma DNA circular de doble cadena (Bradbury, 2005; Gautier-Bouchardon, 2018). Se conocen un total de 25 especies de micoplasmas en aves de corral, dentro de los cuales Mycoplasma gallisepticum (Mg), M. synoviae (Ms), M. meleagridis (Mm) y M. iowae (Mi) son patogénicos.
En los sistemas modernos de producción avícola, la salud intestinal se ha convertido en un pilar clave para garantizar la sanidad, el bienestar y el rendimiento productivo de las aves. Un tracto gastrointestinal funcional no solo es esencial para una adecuada digestión y absorción de nutrientes, sino que también cumple un rol fundamental como barrera física, inmunológica y microbiológica frente a patógenos y toxinas del ambiente.
En los últimos años hemos tratado de entender las fases de la respuesta inmune, la patogénesis y la protección conferida por vacunas frente a los desafíos de Salmonella Enteritidis, pero debemos tener en cuenta que esa respuesta inmune depende del serotipo infectante y de la expresión genética del huésped. La Salmonella Enteritidis y la S. Typhimurium pueden infectar diversos hospedadores.
Los pollos de engorde permanecen sobre la cama del galpón casi todo el ciclo productivo, por lo que mantenerla seca es una parte fundamental en las producciones avícolas y un factor muy influyente en el rendimiento de las aves. La sequedad de esta cama ayuda a controlar los niveles de amoniaco, mantiene un ambiente saludable y reduce la dermatitis en las almohadillas plantares y evita que la pechuga sufra lesiones que disminuyen la calidad de la canal comercial.
La Resistencia Antimicrobiana (RAM) representa uno de los mayores desafíos en la salud pública global, comprometiendo la eficacia de los tratamientos antibióticos y generando un impacto significativo en la medicina humana y veterinaria. Este fenómeno, mediado por elementos genéticos móviles como plásmidos, transposones e integrones, facilita la diseminación de genes de resistencia entre bacterias mediante transferencia horizontal, sin necesidad de replicación bacteriana y contribuye significativamente al fracaso terapéutico en infecciones (Fišarová et al., 2019).
La avicultura constituye uno de los sectores pecuarios de mayor dinamismo y relevancia en la seguridad alimentaria mundial, aportando más del 40 % de la proteína animal consumida globalmente (FAO, 2022). En Colombia, este sector representa un componente estratégico del PIB agropecuario: la Federación Nacional de Avicultores (FENAVI, 2024) reporta una producción anual de 1,8 millones de toneladas de carne de pollo y cerca de 18 mil millones de huevos, con un consumo per cápita estimado de 345 unidades por habitante.
Publireportajes
La bronquitis infecciosa aviar (BI) es una enfermedad viral altamente contagiosa que ocasiona pérdidas económicas significativas en la industria avícola global. En Colombia, donde se ha reportado desde 1963, la enfermedad se presenta principalmente con signos respiratorios en pollos de engorde. Entre 2003 y 2005, se identificaron las cepas GI-1, GI-16, GI-20 y GVI-1; en 2020, se detectaron cepas compatibles con GI-16 y GI-11, siendo esta última la variante predominante, asociada a manifestaciones clínicas respiratorias, infertilidad, disminución en la producción y calidad de la cáscara, trastornos entéricos y nefropatías.
La industria avícola de América del Sur se enfrenta a un importante desafío de micotoxinas, los cuales son metabolitos secundarios nocivos producidos por mohos, que comprometen la salud de las aves de corral, la productividad y la estabilidad económica. Las diversas condiciones climáticas de la región, exacerbadas por el cambio climático, promueven el aumento en la prevalencia de micotoxinas claves como aflatoxinas, fumonisinas, ocratoxinas, zearalenona, tricotecenos, entre otras, que son perjudiciales para la salud avícola y pública.
Tecniplumazos